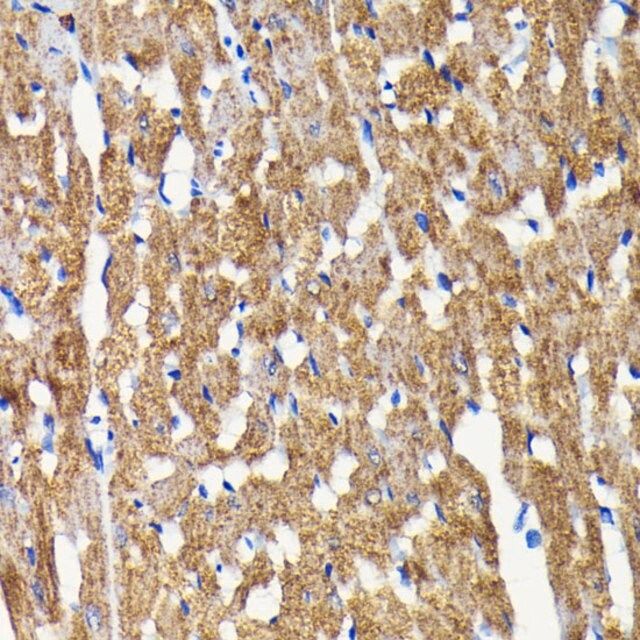

Rabbit Anti-Bnip3 Catalog No 3485-1
Rabbit Anti-Bnip3 Catalog No 3485-1 - It is, perhaps, the most optimistic of all the catalog forms. The widespread use of a few popular templates can, and often does, lead to a sense of visual homogeneity. Once filled out on a computer, the final printable document can be sent to a client, or the blank printable template can be printed out first and filled in by hand. It is a sample not just of a product, but of a specific moment in technological history, a sample of a new medium trying to find its own unique language by clumsily speaking the language of the medium it was destined to replace. 4 This significant increase in success is not magic; it is the result of specific cognitive processes that are activated when we physically write. A variety of warning and indicator lights are also integrated into the instrument cluster. And this idea finds its ultimate expression in the concept of the Design System. Far more than a mere organizational accessory, a well-executed printable chart functions as a powerful cognitive tool, a tangible instrument for strategic planning, and a universally understood medium for communication. The most literal and foundational incarnation of this concept is the artist's value chart. They were a call to action. A printable chart is an excellent tool for managing these other critical aspects of your health. It is still connected to the main logic board by several fragile ribbon cables. Shading and lighting are crucial for creating depth and realism in your drawings. By making gratitude journaling a regular habit, individuals can cultivate a more optimistic and resilient mindset. We have seen how it leverages our brain's preference for visual information, how the physical act of writing on a chart forges a stronger connection to our goals, and how the simple act of tracking progress on a chart can create a motivating feedback loop. Sketching is fast, cheap, and disposable, which encourages exploration of many different ideas without getting emotionally attached to any single one. Each step is then analyzed and categorized on a chart as either "value-adding" or "non-value-adding" (waste) from the customer's perspective. The full-spectrum LED grow light can be bright, and while it is safe for your plants, you should avoid staring directly into the light for extended periods. It democratizes organization and creativity, offering tools that range from a printable invoice for a new entrepreneur to a printable learning aid for a child. 33 For cardiovascular exercises, the chart would track metrics like distance, duration, and intensity level. When a company's stated values on a chart are in direct conflict with its internal processes and reward systems, the chart becomes a hollow artifact, a source of employee disillusionment. The product is shown not in a sterile studio environment, but in a narrative context that evokes a specific mood or tells a story. The "master file" was a painstakingly assembled bed of metal type, and from this physical template, identical copies could be generated, unleashing a flood of information across Europe. Then came typography, which I quickly learned is the subtle but powerful workhorse of brand identity. Impact on Various Sectors Focal Points: Identify the main focal point of your drawing. There are several types of symmetry, including reflectional (mirror), rotational, and translational symmetry. Take advantage of online resources, tutorials, and courses to expand your knowledge. Some common types include: Reflect on Your Progress: Periodically review your work to see how far you've come. To engage it, simply pull the switch up. With the device open, the immediate priority is to disconnect the battery. But I'm learning that this is often the worst thing you can do. A chart can be an invaluable tool for making the intangible world of our feelings tangible, providing a structure for understanding and managing our inner states. The cost of the advertising campaign, the photographers, the models, and, recursively, the cost of designing, printing, and distributing the very catalog in which the product appears, are all folded into that final price. The blank canvas still holds its allure, but I now understand that true, professional creativity isn't about starting from scratch every time. One person had put it in a box, another had tilted it, another had filled it with a photographic texture. It meant a marketing manager or an intern could create a simple, on-brand presentation or social media graphic with confidence, without needing to consult a designer for every small task. A soft, rubberized grip on a power tool communicates safety and control. This inclusivity has helped to break down stereotypes and challenge the perception of knitting as an exclusively female or elderly pastime. Similarly, a simple water tracker chart can help you ensure you are staying properly hydrated throughout the day, a small change that has a significant impact on energy levels and overall health. Similarly, a sunburst diagram, which uses a radial layout, can tell a similar story in a different and often more engaging way. A weekly meal plan chart, for example, can simplify grocery shopping and answer the daily question of "what's for dinner?". 25 Similarly, a habit tracker chart provides a clear visual record of consistency, creating motivational "streaks" that users are reluctant to break. This makes every template a tool of empowerment, bestowing a level of polish and professionalism that might otherwise be difficult to achieve. In contrast, a poorly designed printable might be blurry, have text that runs too close to the edge of the page, or use a chaotic layout that is difficult to follow. He just asked, "So, what have you been looking at?" I was confused. Try cleaning the sensor, which is located inside the basin, with the provided brush. Faced with this overwhelming and often depressing landscape of hidden costs, there is a growing movement towards transparency and conscious consumerism, an attempt to create fragments of a real-world cost catalog. What I've come to realize is that behind every great design manual or robust design system lies an immense amount of unseen labor. 71 Tufte coined the term "chart junk" to describe the extraneous visual elements that clutter a chart and distract from its core message. The psychologist Barry Schwartz famously termed this the "paradox of choice. It would shift the definition of value from a low initial price to a low total cost of ownership over time. My job, it seemed, was not to create, but to assemble. Drawing in black and white also offers artists a sense of freedom and experimentation. Research has shown that exposure to patterns can enhance children's cognitive abilities, including spatial reasoning and problem-solving skills. When the comparison involves tracking performance over a continuous variable like time, a chart with multiple lines becomes the storyteller. Power on the ChronoMark and conduct a full functional test of all its features, including the screen, buttons, audio, and charging, to confirm that the repair was successful. 78 Therefore, a clean, well-labeled chart with a high data-ink ratio is, by definition, a low-extraneous-load chart. The center of your dashboard is dominated by the SYNC 4 infotainment system, which features a large touchscreen display. If your planter is not turning on, first ensure that the power adapter is securely connected to both the planter and a functioning electrical outlet. A classic print catalog was a finite and curated object. It’s asking our brains to do something we are evolutionarily bad at. 10 The underlying mechanism for this is explained by Allan Paivio's dual-coding theory, which posits that our memory operates on two distinct channels: one for verbal information and one for visual information. 39 This empowers them to become active participants in their own health management. Communication with stakeholders is a critical skill. The lap belt should be worn low and snug across your hips, not your stomach, and the shoulder belt should cross your chest and shoulder. Services like one-click ordering and same-day delivery are designed to make the process of buying as frictionless and instantaneous as possible. The same principle applies to global commerce, where the specifications for manufactured goods, the volume of traded commodities, and the dimensions of shipping containers must be accurately converted to comply with international standards and ensure fair trade. As I navigate these endless digital shelves, I am no longer just a consumer looking at a list of products. The VDC system monitors your steering and braking actions and compares them to the vehicle’s actual motion. This system is your gateway to navigation, entertainment, and communication. It is the quintessential printable format, a digital vessel designed with the explicit purpose of being a stable and reliable bridge to the physical page. This data can also be used for active manipulation. A true cost catalog for a "free" social media app would have to list the data points it collects as its price: your location, your contact list, your browsing history, your political affiliations, your inferred emotional state. These prompts can focus on a wide range of topics, including coping strategies, relationship dynamics, and self-esteem. 58 Ultimately, an ethical chart serves to empower the viewer with a truthful understanding, making it a tool for clarification rather than deception. They don't just present a chart; they build a narrative around it. It is a sample not just of a product, but of a specific moment in technological history, a sample of a new medium trying to find its own unique language by clumsily speaking the language of the medium it was destined to replace. Postmodernism, in design as in other fields, challenged the notion of universal truths and singular, correct solutions.AntiBNIP3 Antibody (A14904)
BNIP3 Protein Suppresses PINK1 Kinase Proteolytic Cleavage to Promote
AntiBNIP3 antibody [ANa40](AB10433)
AntiBNIP3 Antibody (A14904)
KDValidated AntiBNIP3 Rabbit Monoclonal Ab 64885 GenuIN Biotech
BNIP3 Rabbit mAb SAB Signalway Antibody
BNIP3 Monoclonal Antibody (8H14L2) (701696)
AntiBNIP3 Rabbit mAb
赛维尔生物服务产品_Servicebio_武汉赛维尔生物科技有限公司
BNIP3 Monoclonal Antibody (ANa40) (MA124688)
BNIP3 Rabbit mAb SAB Signalway Antibody
AntiBNIP3 Antibody (A14904)
Activation of Ras Upregulates Proapoptotic BNIP3 in Nitric Oxide
AntiBNIP3 Rabbit mAb [77L55M82]
赛维尔生物服务产品_Servicebio_武汉赛维尔生物科技有限公司
ULK1 promotes mitophagy via phosphorylation and stabilization of BNIP3
AntiBNIP3 antibody produced in rabbit
BNIP3 antibody (680911Ig) Proteintech
Rabbit Monoclonal Antibody Development Leinco Technologies
BNIP3 antibody (CL48868091) Proteintech
BNIP3 pSer131 polyclonal antibody and preparation method and
BNIP3 Ab Abways
Expression and regulatory mechanism of BNIP3 in clear cell
AntiBNIP3 Antibody (A14904)
BNIP3 Polyclonal Antibody (PA596388)
AntiBNIP3 Rabbit mAb [77L55M82]
AntiBNIP3 antibody [ANa40] (Alexa Fluor® 647) ab196706
ANTIBNIP3 ANTIBODY
AntiBNIP3 antibody produced in rabbit
AntiBNIP3 Antibody (A14904)
AntiBNIP3 Rabbit mAb
BNIP3 Superclonal Antibody (8HCLC) (710728)
赛维尔生物服务产品_Servicebio_武汉赛维尔生物科技有限公司
BNIP3 Antibody (BH3 Domain Specific) Purified Rabbit Polyclonal
Related Post:


](https://www.abcam.com/ps/products/10/ab10433/Images/ab10433-391090-anti-bnip3-antibody-immunohistochemistry-kidney-human.jpg)










![AntiBNIP3 Rabbit mAb [77L55M82]](https://files.epizyme.cn:5005/uploads/antybody/R012826_1.jpg)











![AntiBNIP3 Rabbit mAb [77L55M82]](https://files.epizyme.cn:5005/uploads/antybody/R012826_3.jpg)
![AntiBNIP3 antibody [ANa40] (Alexa Fluor® 647) ab196706](https://s2.studylib.net/store/data/012083394_1-2ff7db27c0d6912ecfc1f982c1a7d990-768x994.png)